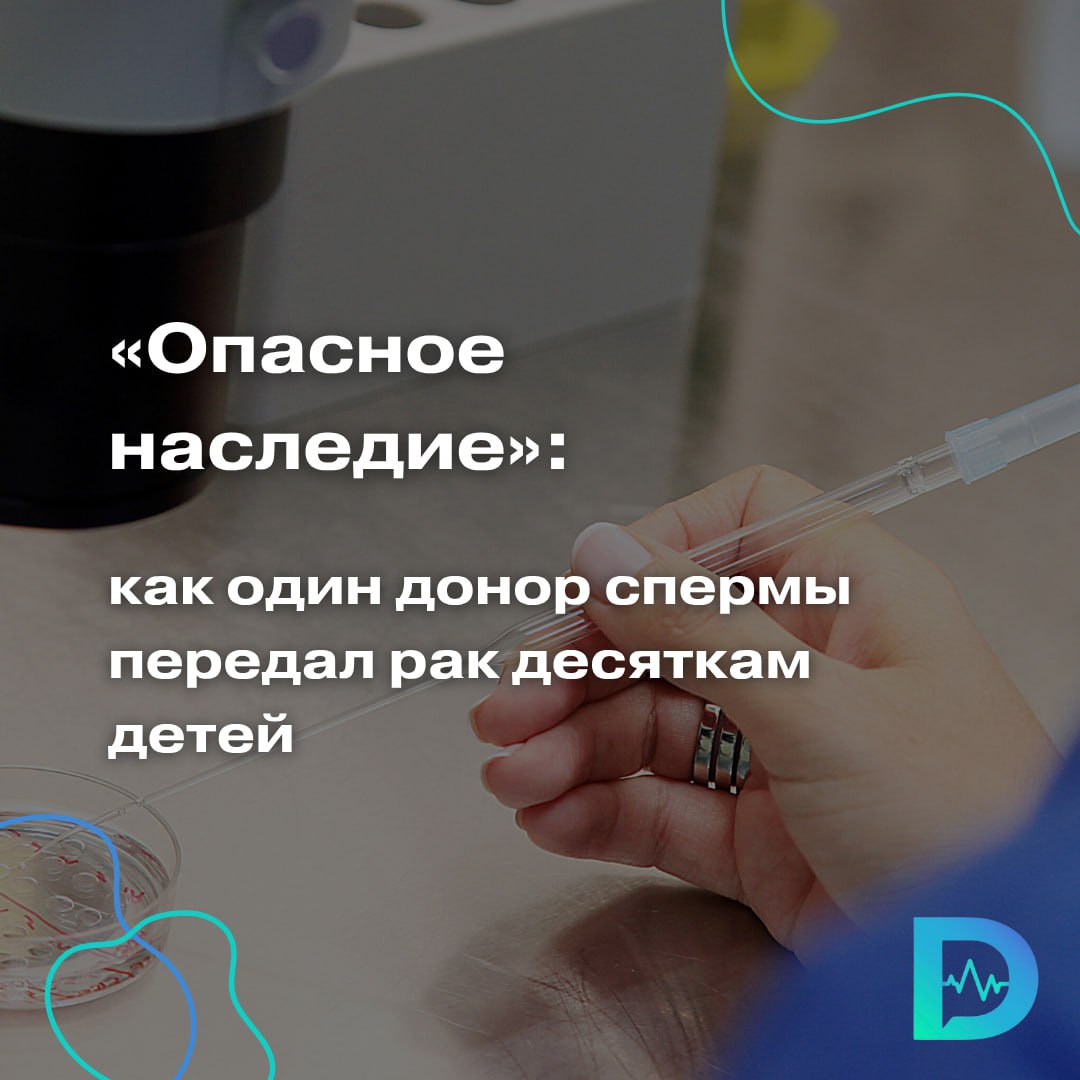
В Европе разгорается громкий скандал: донор спермы, не знавший о наличии у себя редкой генетической мутации, стал биологическим отцом по меньшей мере 67 детей в восьми странах. У десятерых уже диагностировали рак, включая опухоли мозга и лимфомы. У ещё 17 детей выявлена та же мутация, но пока без признаков болезни. Эти данные были представлены на конференции Европейского общества генетики человека в Милане. Речь идёт о мутации в гене TP53, которая вызывает синдром Ли-Фраумени. Это редкое наследственное заболевание, связанное с высоким риском развития рака в молодом возрасте. Его носители могут заболеть в детстве, и часто сразу несколькими видами рака. Проблема в том, что на момент сдачи спермы в 2008 году в Дании тесты на подобные мутации попросту не проводились. Донор и сам чувствует себя здоровым — вероятно, у него мозаичная форма мутации, при которой генетическая ошибка есть только в части клеток. История вызвала резонанс и поставила под сомнение существующие подходы к контролю в сфере репродуктивных технологий. Как быть в случаях, когда опасные мутации в сперме обнаруживаются только десятилетия спустя, как предупредить всех родившихся, кто отвечает за проблему — в целом решительно неясно. Банки спермы почти всегда ограничивают количество родившихся от одного донора в одной стране или районе, но стран много, банков много, не все оплодотворения даже идут через банки, и не все страны ограничивают искусственное оплодотворение иностранок спермой одного и того же донора, — комментирует новость учёный-генетик Дмитрий Прусс. Специалисты призывают срочно ужесточить правила: ввести международные ограничения на число детей от одного донора, внедрить обязательный скрининг и улучшить обратную связь между клиниками и семьями. «Доктор Питер». Доступно и достоверно о здоровье

30 мая, 08:21
Сперма донора с мутацией, связанной с раком, использована для зачатия 67 детей в Европе



Боги маркетинга
В Европе донор с плохой мутацией гена TP53 стал биологическим отцом как минимум 67 детей — и у 10 из них уже диагностировали рак. На момент сдачи спермы в 2008 году о связи этого гена с высоким риском онкологии ещё не знали, а стандартные скрининги такие мутации не выявляли. Теперь ученые бьют тревогу: сперма одного донора — слишком высокая ставка. Предлагается жёстко ограничить число зачатий — максимум 75 семей, чтобы избежать таких случаев. Кажется, пора не только проверять Дурова и Маска, но и в целом пересматривать, как работает «фабрика гениев» в пробирке.


Своими Глазами
Сперма донора с высоким риском заболевания раком была использована для зачатия как минимум 67 детей. Случай произошёл в Европе: мужик с редкой мутацией, вызывающей рак, стал донором для 67 детей. У 10 из 67 впоследствии диагностировали рак. На момент донорства в 2008 году ещё не было неизвестно, что ген TP53 связан с риском рака и его нельзя было обнаружить стандартными скрининговыми исследованиями. Теперь учёные требуют ограничить количество зачатий с помощью спермы одного донора — пока установлен лимит до 75 семей. ≈≈≈≈≈≈≈≈≈≈≈≈≈≈≈≈≈≈≈≈≈≈≈≈ Boost Глаз Босса VPNTYPE

PCR.NEWS
На конференции Европейского общества генетики человека прозвучал доклад об ужасающем случае — от донора с не выявленным вовремя мозаицизмом спермы родилось не менее 23 детей с вероятно патогенным вариантом в гене TP53. У десяти из них уже развились онкозаболевания, ассоциированные с этой мутацией, а всего у этого человека не менее 67 биологических детей. Докладчица убеждена, что одной из причин этого случая стали пробелы в правовом регулировании, из-за которых использовать гаметы одного донора могут до 75 семей в разных странах. Подробнее #новости


Картотека
Минимум 67 детей по всей Европе были зачаты от донора спермы с редкой мутацией. У десятерых из них выявили рак Сперма донора была использована для зачатия детей из 46 семей, родившихся в период с 2008 по 2015 год. Об этом пишет CNN со ссылкой на Эдвижу Каспер, биолога из университетской больницы Руана во Франции. Выяснилось, что у донора была редкая мутация в гене TP53, которая вызывает синдром Ли-Фраумени — редкое заболевание, повышающее риск развития рака. Дети, рожденные от этого донора, живут в Бельгии, Дании, Франции, Германии, Греции, Испании, Швеции и Великобритании. У десятерых диагностированы раковые заболевания, включая опухоль головного мозга и лимфому Ходжкина Картотека Все по полочкам


On ♾ Air
Сперма донора с высоким риском заболевания раком была использована для зачатия как минимум 67 детей. Случай произошёл в Европе: мужик с редкой мутацией, вызывающей рак, стал донором для 67 детей. У 10 из 67 впоследствии диагностировали рак. На момент донорства в 2008 году ещё не было неизвестно, что ген TP53 связан с риском рака и его нельзя было обнаружить стандартными скрининговыми исследованиями. Теперь учёные требуют ограничить количество зачатий с помощью спермы одного донора — пока установлен лимит до 75 семей. ≈≈≈≈≈≈≈≈≈≈≈≈≈≈≈≈≈≈≈≈≈≈≈≈ Boost Глаз Босса VPNTYPE


QWERTY
Донор спермы с редким геном рака стал отцом 67 детей в 8 странах Европы Сперма мужчины с редкой раковой мутацией использовалась для зачатия 67 детей в 8 странах Европы. По данным исследований, 23 ребёнка, зачатых с 2008 по 2015 год, унаследовали этот ген. К сожалению, у 10 из них впоследствии развились онкологические заболевания, включая лейкемию и неходжкинскую лимфому. Проблему обнаружили, когда две семьи обратились в клиники из-за онкологии у детей. Анализ показал мутацию в гене TP53, который подавляет опухоли. Когда донор сдавал сперму в 2008 году, связь этой мутации с онкологией ещё не была известна, и стандартные тесты её не выявляли. Сам донор, по имеющимся данным, здоров. Европейский банк спермы ограничивает число семей на донора 75, но точное количество детей не раскрывается. Сейчас нет международных норм, регулирующих использование спермы. Учёные призывают ввести лимиты.


Вечерний Телеграмъ
В Европе сперму донора с высоким риском заболевания раком использовали для зачатия 67 детей У десяти детей уже выявили онкологические заболевания, в том числе лейкемию. Мутация спермы приводит к синдрому Ли-Фраумени — наследственной предрасположенности к онкологическим заболеваниям. Биоматериал предоставлял Европейский банк спермы. При этом она сдавалась в 2008 году, тогда еще не было известно о том, что такой вариант связан с раком. Считалось, что донор здоров, а мутацию нельзя было выявить при стандартных тестах. После инцидента европейские чиновники предложили установить ограничения по количеству рождений детей от одного донора. По их мнению, эта мера будет действовать до тех пор, пока не удастся провести полный анализ ДНК всех доноров. #общество #мир #европа #происшествия

Доктор Питер
В Европе разгорается громкий скандал: донор спермы, не знавший о наличии у себя редкой генетической мутации, стал биологическим отцом по меньшей мере 67 детей в восьми странах. У десятерых уже диагностировали рак, включая опухоли мозга и лимфомы. У ещё 17 детей выявлена та же мутация, но пока без признаков болезни. Эти данные были представлены на конференции Европейского общества генетики человека в Милане. Речь идёт о мутации в гене TP53, которая вызывает синдром Ли-Фраумени. Это редкое наследственное заболевание, связанное с высоким риском развития рака в молодом возрасте. Его носители могут заболеть в детстве, и часто сразу несколькими видами рака. Проблема в том, что на момент сдачи спермы в 2008 году в Дании тесты на подобные мутации попросту не проводились. Донор и сам чувствует себя здоровым — вероятно, у него мозаичная форма мутации, при которой генетическая ошибка есть только в части клеток. История вызвала резонанс и поставила под сомнение существующие подходы к контролю в сфере репродуктивных технологий. Как быть в случаях, когда опасные мутации в сперме обнаруживаются только десятилетия спустя, как предупредить всех родившихся, кто отвечает за проблему — в целом решительно неясно. Банки спермы почти всегда ограничивают количество родившихся от одного донора в одной стране или районе, но стран много, банков много, не все оплодотворения даже идут через банки, и не все страны ограничивают искусственное оплодотворение иностранок спермой одного и того же донора, — комментирует новость учёный-генетик Дмитрий Прусс. Специалисты призывают срочно ужесточить правила: ввести международные ограничения на число детей от одного донора, внедрить обязательный скрининг и улучшить обратную связь между клиниками и семьями. «Доктор Питер». Доступно и достоверно о здоровье
Похожие новости



+5



+3



+3



+7







+3

Всемирный день борьбы с меланомой: важность ранней диагностики и акции в Калининграде
Общество
14 часов назад


+5
В Кузбассе введены ограничения из-за вспышки заболевания скота
Наука
11 часов назад


+3
Снижение числа абортов в Калужской области: 700 случаев в 2025 году
Происшествия
16 часов назад


+3
Британские пассажиры круизного лайнера MV Hondius изолированы в больнице после вспышки хантавируса
Происшествия
16 часов назад


+7
Смертельный хантавирус угрожает украинским пограничникам на фоне коррупционного скандала
Происшествия
7 часов назад



Трое детей пострадали в ДТП в Сакском районе Крыма
Происшествия
7 часов назад


+3